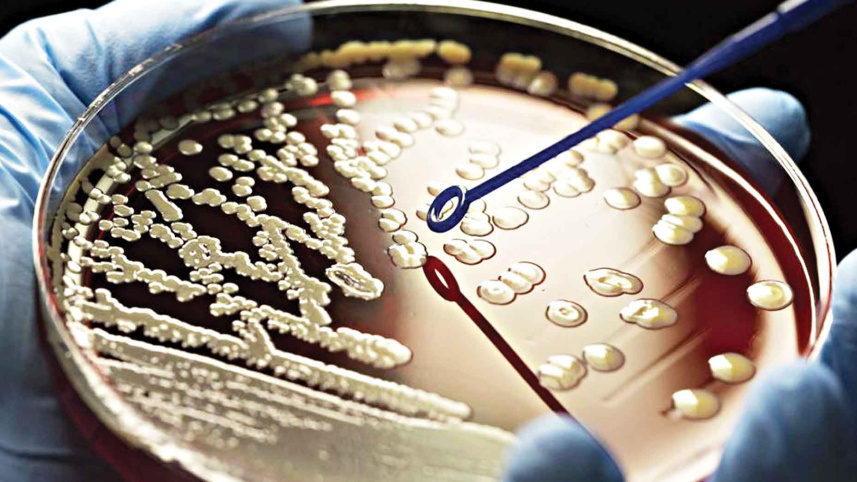
typhoid-causing-bacteria.jpg

Typhoid-causing bacteria have become increasingly resistant to essential antibiotics and have spread widely over past 30 years
According to a study in The Lancet Microbe, Typhoid-causing bacteria are becoming resistant to necessary antibiotics. The largest genome analysis of S. Typhi reveals that resistant strains, almost all from South Asia, have spread nearly 200 times since 1990. Typhoid fever causes 11 million infections and 100,000 deaths annually. South Asia accounts for 70% of the global disease burden, but it also affects sub-Saharan Africa, Southeast Asia, and Oceania, requiring a global response. Antibiotics can treat typhoid fever, but resistant S. Typhi strains threaten their effectiveness. Most studies on the spread of resistant S. Typhi have used small samples.
Researchers collected 3,489 S. Typhi blood samples from Bangladesh, India, Nepal, and Pakistan with confirmed typhoid fever between 2014 and 2019. 4,169 S.Typhi samples from more than 70 countries were sequenced and analysed. Genetic databases identified resistant-conferring genes in 7,658 sequenced genomes. Multidrug-resistant (MDR) strains contained ampicillin, chloramphenicol, and trimethoprim/sulfamethoxazole-resistant genes. The authors also found genes conferring resistance to macrolides and quinolones, two essential antibiotics.
Since 1990, resistant S. Typhi strains have spread 197 times. These strains have been found in South Asia, Southeast Asia, East and Southern Africa, the UK, the USA, and Canada. Since 2000, MDR S. Typhi has declined in Bangladesh, India, and Nepal (less than 5% of Typhoid strains) but increased in Pakistan.
However, antibiotic-resistant strains are replacing them. Since 1990, quinolone-resistant gene mutations have arisen and spread at least 94 times, with 97% originating in South Asia. Quinolone-resistant strains made up over 85% of S. Typhi in Bangladesh in the early 2000s and 95% in India, Pakistan, and Nepal by 2010. At least seven mutations have caused azithromycin resistance in the past 20 years. In 2013, mutation-containing strains emerged in Bangladesh, and their population has grown. The findings add to recent evidence of the rapid rise and spread of S. Typhi strains resistant to third-generation cephalosporins.
The lead author says: "In recent years, highly resistant strains of S. Typhi have emerged and spread quickly, highlighting the need to expand prevention measures, especially in high-risk countries." Resistant strains of S. Typhi have spread internationally so often, highlighting the need to view typhoid control and antibiotic resistance as a global problem."


 For all latest news, follow The Daily Star's Google News channel.
For all latest news, follow The Daily Star's Google News channel.
Comments